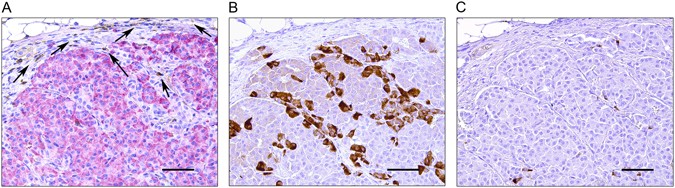
Figure 5

Figure 5
Long-term preservation of beta cell function in HU-SRC-SCID mice transplanted with LEA29Y expressing NPICCs. Xenograft was harvested 29 weeks post transplantation and stained for (A) human CD45 (brown) and insulin (red), (B) glucagon (brown) and (C) somatostatin (brown). Local LEA29Y expression preserved ICC structure and restricted human immune infiltration to the periphery of the transplantation site. Scale bar: 100 μm.